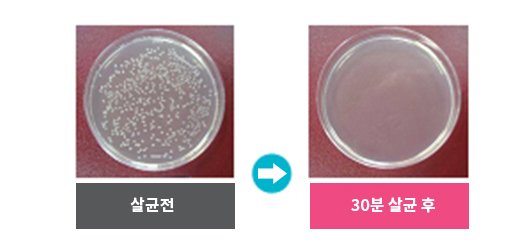

PRODUCT RAY-DOC의 제품을 소개합니다.

Ray-Doc 살균기
컴팩트한 사이즈!
사무실, 가정용 어디서든 간편하게~
인체유해성이 적은 근자외선 LED 사용.
살균력 공인인증! 믿고 쓰는 살균기
01 마우스, 휴대폰 등에 묻어있는 세균들!
생활속의 세균들에서 항상 쓰이는 많은 소형가전, 세균으로 인해 각종 질병에 전염될 수 있습니다!

여럿이서 쓰는 지폐, 하루 몇시간씩 손에 쥐고있는 휴대폰,
마우스, 리모콘, 우리아이 장난감 등..
내 손에 가까이 있는 물건들에 세균들이!
스마트폰이 쏙 들어가는 Ray-Doc 살균기로 안심하고 사용하세요~
02 안전한 레이닥 살균기!

이용 중 자외선에 노출되지 않아 안전합니다.
안전스위치로 받침대와 살균기가 떨어지면 자동으로 일시정지!
03 실용적인 디자인

살균 중에도 휴대폰 충전이 가능합니다.
휴대용품이 쏙 들어가는 알맞은 사이즈!
열배출도 고려한 디자인!
04 쉽고 편리한 사용

연속모드(연속살균)와 강화모드(30분 살균) 설정으로 편의에 맞게 사용하세요.
받침대에 광촉매 코팅이 되어있어 살균효과가 더욱 커졌습니다.
05 Ray-Doc 살균기 살균력 실험
살균력 99.9%
한국건설생활환경시험연구원 테스트 결과, 대장균을 30분간 살균시 99.9% 살균되었습니다.
05 시험성적서

제품사양, 규격 Product Specification
| 제품크기 | 220x120x60 ㎜ (WxDxH) |
|---|---|
| 입력전압 | AC 100-240V |
| 출력전압 | DC 12V / 1.5A |
| 타이머 | 30분 / 연속 |
